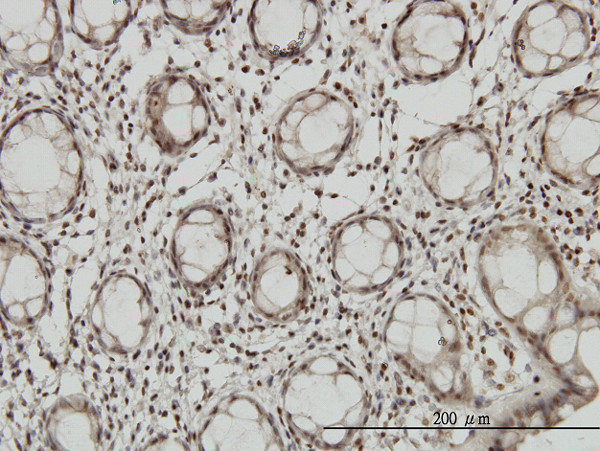
DLX2 Antibody in Immunohistochemistry (Paraffin) (IHC (P))

Search
Abnova
DLX2 Monoclonal Antibody (2E12)
{{$productOrderCtrl.translations['antibody.pdp.commerceCard.promotion.promotions']}}
{{$productOrderCtrl.translations['antibody.pdp.commerceCard.promotion.viewpromo']}}
{{$productOrderCtrl.translations['antibody.pdp.commerceCard.promotion.promocode']}}: {{promo.promoCode}} {{promo.promoTitle}} {{promo.promoDescription}}. {{$productOrderCtrl.translations['antibody.pdp.commerceCard.promotion.learnmore']}}
产品信息
H00001746-M05
宿主/亚型
分类
类型
克隆号
抗原
偶联物
形式
浓度
规格
保存条件
运输条件
产品详细信息
Sequence of this protein is as follows: MTGVFDSLVA DMHSTQIAAS STYHQHQQPP SGGGAGPGGN SSSSSSLHKP QESPTLPVST ATDSSYYTNQ QHPAGGGGGG GSPYAHMGSY QYQASGLNNV PYSAKSSYDL
靶标信息
Many vertebrate homeo box-containing genes have been identified on the basis of their sequence similarity with Drosophila developmental genes. Members of the Dlx gene family contain a homeobox that is related to that of Distal-less (Dll), a gene expressed in the head and limbs of the developing fruit fly. The Distal-less (Dlx) family of genes comprises at least 6 different members, DLX1-DLX6. The DLX proteins are postulated to play a role in forebrain and craniofacial development. This gene is located in a tail-to-tail configuration with another member of the gene family on the long arm of chromosome 2.
仅用于科研。不用于诊断过程。未经明确授权不得转售。